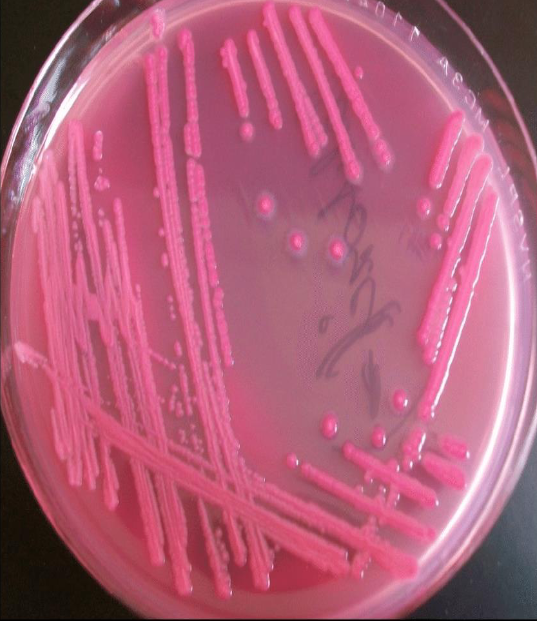
<p>Какво е характерно за Е. coli?</p>

1/8
Looks like no tags are added yet.
Name | Mastery | Learn | Test | Matching | Spaced |
|---|
No study sessions yet.
Какво е характерно за Е. coli?
сем. Enterobacteriaceae, род Escherichia
грам-отрицателни прави пръчици
разположението на клетките е нехактерно – поединично, по двойки или в неправилни
формации
перитрихи, но се срещат и неподвижни щамове
не образуват спори
повечето образуват капсули или микрокапсули
аероби, факултативни анаероби
невзискателни

Антигенна структура:
О-антигени
Н-антигени
F-антигени
K-антигени
Фактори на патогенност и вирулентност:
Ендотоксин
Екзотоксини
Ентеротоксини (ST, LT…)
Цитолитични токсини ( Vero-toxin…)
Фимбрии ( пили )
Капсулни антигени – (О1….)
Етиология и епидемиология (предаване):
част от нормалната флора в дисталните отдели на ГИТ още от раждането
входна врата – устна кухина
механизъм – фекално-орален
Заболявания:
Неонатален менингит – водещ причинител е
E.coli, септицемия и висока смъртност
Гастроентерити
уроинфекции
сепсис
Патогенеза на гастроенетеритите:
ентеротоксигенни E. coli (ETEC)
ентероинвазивни E. coli (EIEC)→диарогенни
ентеропатогенни E. coli (EPEC)→диарийни заболявания;предимно при новородени и деца в ранна детска възраст, с висока смъртност
ентероагрегативни E. coli (EAEC)
ентерохеморагични E. coli (EHEC)
Материали за изследване:
фецес
урина
секрети (вагинален,
ушен, очен, гърлен, раневи)
ликвор и кръв
аутопсионен
материал
Лбораторна диагностика:
Микроскопско изследване на клиничния материал се прави по изключение само ако има диагностична стойност (ликвор,
раневи секрет)
Използват се кръвен агар, диференциращи хранителни среди,Клиглер
От съществено значение е антигенния анализ на E.coli.
Използва се аглутинация тип Грубер с ОК-анти E.coli серуми
Антибиограма. Като част от нормалната микрофлора E.coli са резервоар на R-плазмиди
Лечение и профилактика:
Имунопрофилактични и имунотерапевтични средства не се използват. Ключово е провеждането на санитарно-епидемични мероприятия
Широкоспектърни бета-лактами, аминогликозиди, триметоприм, имипенем, но след антибиограма, поради възможната полирезистентност